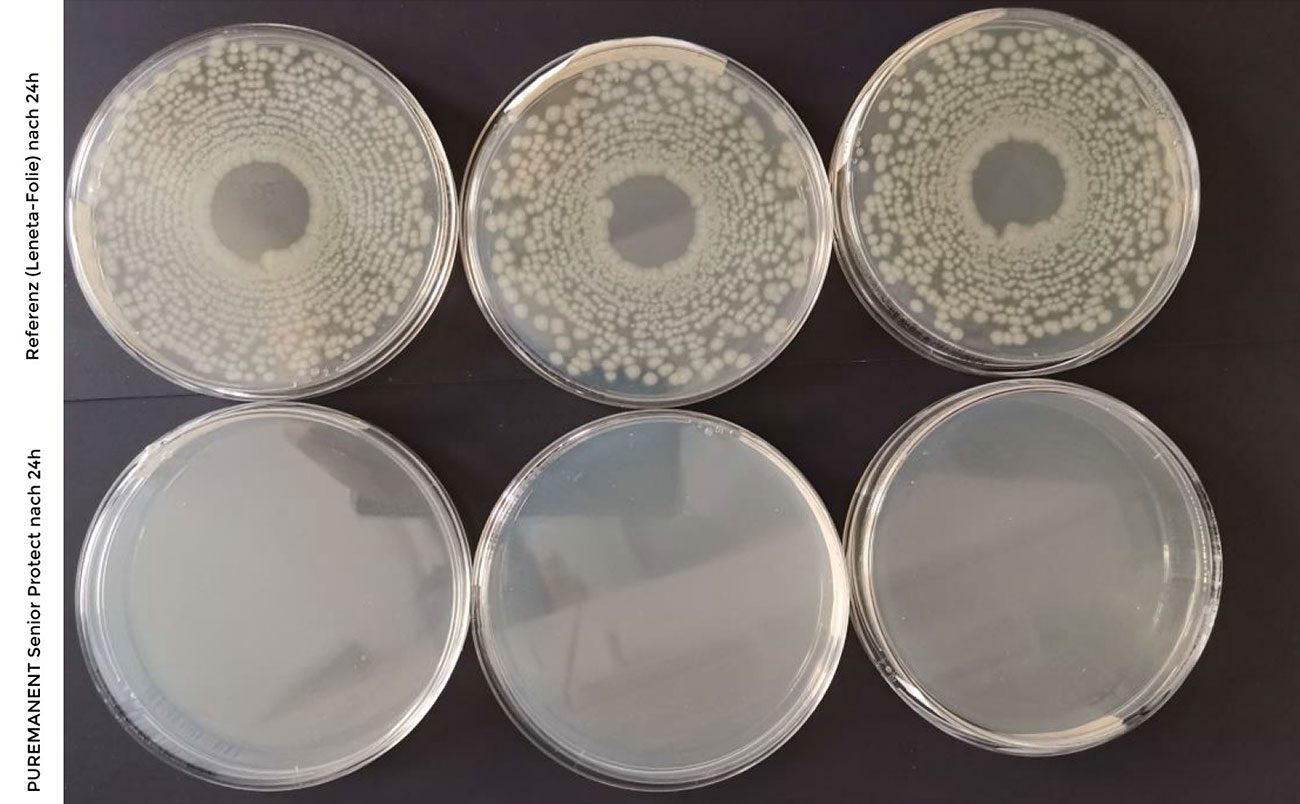

- Kostenloser Versand ab 29€ in Deutschland
Zum Schutz derer die uns immer begleitet haben – Senior Protect

Die besondere Wertschätzung derer, die uns unser Leben lang begleitet haben, liegt darin, sie zu schützen.
PUREMANENT Senior Protect schenkt den Schutz den sie benötigen.

Bessere Hygiene für die Bedürfnisse in der Pflege
In der Pflegebranche ist die Infektionsvermeidung das A und O. Jeden Tag stehen Pflegekräfte vor neuen Herausforderungen. Zum Glück gibt es noch Menschen, die sich um ältere und kranke Personen kümmern. Das möchten wir gern unterstützen, indem das wertvolle Pflegepersonal bestmöglich unterstützt wird und gleichzeitig Infektionsrisiken für Patienten reduziert werden.
Deshalb gibt es NEU ab 24.04.2024 das Flächendesinfektionsmittel PUREMANENT Senior Protect, das speziell für die Bedürfnisse in der ambulanten und stationären Pflege entwickelt wurde:
- Für Pflegegeräte, Therapiegeräte, Medizingeräte, Einrichtungsgegenstände und Flächen aller Art
- Es entlastet Pflegepersonal, weil es die Hygiene bei minimalem Aufwand aufrechterhält.
- Es schützt Patienten mit gemindertem Allgemeinzustand und Krankheiten besser als herkömmliche Desinfektionsmittel.
- Es spart Zeit.
- Es ist budgetschonend.
- Es ist als Schnelldesinfektionsmittel von der VAH zertifiziert
Was macht unser Produkt so einzigartig?
Professionelle Desinfektion

Ein weiterer Pluspunkt ist seine Vielseitigkeit. Als gebrauchsfertige, wasserbasierte Lösung eignet es sich für alle Materialien, von Metallen über Kunststoffe bis hin zu Acrylglas. Dadurch ist es nicht nur für die Desinfektion von Pflegegeräten und Medizinprodukten geeignet, sondern auch für sämtliche Oberflächen in der Einrichtung, einschließlich Arbeitsflächen, Türklinken und Handläufen. Doch der eigentliche Wert liegt nicht nur in seiner Wirksamkeit, sondern auch in seiner Benutzerfreundlichkeit. Indem es die hygienischen Standards mit minimalem Aufwand aufrechterhält, entlastet es das Pflegepersonal und ermöglicht es ihnen, sich vollkommen auf die Betreuung der Patienten und Bewohner zu konzentrieren.
PUREMANENT Senior Protect wurde zur effektiveren Infektionsverhütung entwickelt, indem es die Keimweitergabe durch Oberflächen stoppt und Kreuzkontaminationen verhindert. Sein nachhaltig wirkender biozider Effekt gegen Viren, Bakterien und Pilze ist unsichtbar und klebt nicht. Damit erzeugt das Produkt einen effektiveren Infektionsschutz, als es herkömmliche Produkte machen.
Zusammenfassend ist PUREMANENT Senior Protect mehr als nur ein Desinfektionsmittel – es ist eine Revolution in der Pflegehygiene. Dank seiner einzigartigen Kombination aus Wirksamkeit, Vielseitigkeit und Benutzerfreundlichkeit schafft es eine sicherere und gesündere Umgebung für Bewohner und Pflegekräfte gleichermaßen.

Wir haben Ihr Interesse geweckt? Probieren Sie.
Testen Sie jetzt unser neues PUREMANENT Senior Protect Flächendesinfektionsmittel. Es lohnt sich und Sie werden begeistert sein.